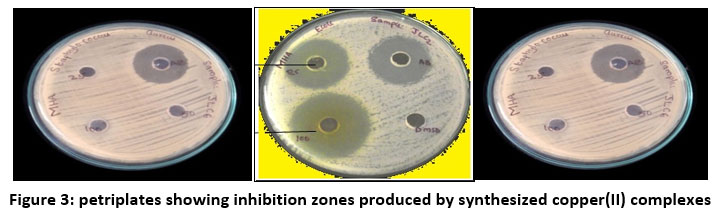
Orienjchem's tweet image. Synthesis, Spectral, Antimicrobial and In Vitro Antitumorous Studies of Copper Based Mulltidentate Thiosemicarbazones.
bit.ly/3KtZO8A
#Antitumorousstudies #Coppercomplexes #EPRspectra #gvalues #multidentate #chemistry #biochemistry #nanomaterial #analyticalchemistry

#coppercomplexes search results
Today is my invited lecture titled #SolidStateNMR from small molecules to complex materials at @germn_rseq I will show what @lazarolab is doing in #NMR! #CopperComplexes #Materials


Evaluation of Membrane Permeability of Copper-Based Drugs Evariste Umba-Tsumbu 1 , Ahmed N. Hammouda 1,2 and Graham Ellis Jackson 1,* 1 University of Cape Town, South Africa 2 University of Benghazi, Libya @MDPIOpenAccess @UCT_Research @RoySocChem @NRF_News @UCT_news

Palanquin-Like Cu4Na4 Silsesquioxane Synthesis (via Oxidation of 1,1-bis(Diphenylphosphino)methane), Structure and Catalytic Activity in Alkane or Alcohol Oxidation with Peroxides sci.fo/5tf #Alkanes #HydrogenPeroxide #CopperComplexes

New Paper! @ChemBioChem #Isoxazole‐Derived #Aroylhydrazones &Their Dinuclear #CopperComplexes Show #Antiproliferative Activity on #BreastCancer Cells with a Potentially Alternative Mechanism Of Action …mistry-europe.onlinelibrary.wiley.com/doi/epdf/10.10… Rt @IPCM_Sorbonne @pucriooficial #medicinalchemistry
Synthesis, Spectral, Antimicrobial and In Vitro Antitumorous Studies of Copper Based Mulltidentate Thiosemicarbazones. bit.ly/3KtZO8A #Antitumorousstudies #Coppercomplexes #EPRspectra #gvalues #multidentate #chemistry #biochemistry #nanomaterial #analyticalchemistry

Petrenko et al.: Crystal structure and Hirshfeld-surface analysis of diaquabis(5-methyl-1H-1,2,4-triazole-3-carboxylato)copper(II) #Copper #CopperComplexes #CrystalStructure ... #IUCr scripts.iucr.org/cgi-bin/paper?…
📢Microwave synthetized mono- and bis-chlorinated amino acid Schiff base #CopperComplexes show #antibacterial activity. ➡️Read more at: mdpi.com/2673-8007/2/2/…

So proud to be the first author of our last great review now out on Coordination Chemistry Reviews #coppercomplexes #peptides #dopamine #CCR #unipv. Click here NOW and enjoy the article for FREE authors.elsevier.com/c/1fZd62Tz3xQ0w sciencedirect.com/science/articl…
Efficient Red Electroluminescent Copper Complexes with Fluorination-Balanced Dual Emission. Click the link below to read this free, open access article. doi.org/10.34133/resea… #OLED #LuminescentMaterials #CopperComplexes #OpticalMaterials

Color-tunable #CopperComplexes: Applications in solution-processed #OLEDs. Che @HKUniversity doi.wiley.com/10.1002/asia.2…

Boulguemh et al.: Synthesis, crystal structure and Hirshfeld surface analysis of [Cu(H2L)2(μ-Cl)CuCl3]·H2O [H2L = 2-hydroxy-N′-(propan-2-ylidene)benzohydrazide] #Hydrazone #CrystalStructure #CopperComplexes ... #IUCr journals.iucr.org/paper?S2056989…
Konstantin just presented his research on #coppercomplexes for #ATRP at #ACSSpring2024 ! read online here: pubs.rsc.org/en/content/art… @DaltonTrans Moreover he presented new results on teaching #FAIRdata in chemistry @NFDI4Chem !


#Article Experimental-Theoretical Approach for the Chemical Detection of Glyphosate and Its Potential Interferents Using a Copper Complex Fluorescent Probe by Guilherme Martins, et al. doi.org/10.3390/chemos… @MDPIOpenAccess @unb_oficial @TUChemnitz @ULisboa_ #coppercomplexes

[Coordination Asymmetry] Arsenic | Copper | Cuprophilic interaction Article by Prof. Kensuke Naka and Dr. Hiroaki Imoto @pr_kit (Kyoto Institute of Technology) is available as Open Access #OrganoArsenic #CopperComplexes #Luminescence journal.csj.jp/doi/abs/10.124…
![CSJjournals_jp's tweet image. [Coordination Asymmetry]
Arsenic | Copper | Cuprophilic interaction
Article by Prof. Kensuke Naka and Dr. Hiroaki Imoto @pr_kit (Kyoto Institute of Technology) is available as Open Access
#OrganoArsenic #CopperComplexes #Luminescence
journal.csj.jp/doi/abs/10.124…](https://pbs.twimg.com/media/FFafRljaMAAP_PD.jpg)
Efficient Red Electroluminescent Copper Complexes with Fluorination-Balanced Dual Emission. Click the link below to read this free, open access article. doi.org/10.34133/resea… #OLED #LuminescentMaterials #CopperComplexes #OpticalMaterials

#Article Experimental-Theoretical Approach for the Chemical Detection of Glyphosate and Its Potential Interferents Using a Copper Complex Fluorescent Probe by Guilherme Martins, et al. doi.org/10.3390/chemos… @MDPIOpenAccess @unb_oficial @TUChemnitz @ULisboa_ #coppercomplexes

Boulguemh et al.: Synthesis, crystal structure and Hirshfeld surface analysis of [Cu(H2L)2(μ-Cl)CuCl3]·H2O [H2L = 2-hydroxy-N′-(propan-2-ylidene)benzohydrazide] #Hydrazone #CrystalStructure #CopperComplexes ... #IUCr journals.iucr.org/paper?S2056989…
Konstantin just presented his research on #coppercomplexes for #ATRP at #ACSSpring2024 ! read online here: pubs.rsc.org/en/content/art… @DaltonTrans Moreover he presented new results on teaching #FAIRdata in chemistry @NFDI4Chem !


Petrenko et al.: Crystal structure and Hirshfeld-surface analysis of diaquabis(5-methyl-1H-1,2,4-triazole-3-carboxylato)copper(II) #Copper #CopperComplexes #CrystalStructure ... #IUCr scripts.iucr.org/cgi-bin/paper?…
Synthesis, Spectral, Antimicrobial and In Vitro Antitumorous Studies of Copper Based Mulltidentate Thiosemicarbazones. bit.ly/3KtZO8A #Antitumorousstudies #Coppercomplexes #EPRspectra #gvalues #multidentate #chemistry #biochemistry #nanomaterial #analyticalchemistry

Evaluation of Membrane Permeability of Copper-Based Drugs Evariste Umba-Tsumbu 1 , Ahmed N. Hammouda 1,2 and Graham Ellis Jackson 1,* 1 University of Cape Town, South Africa 2 University of Benghazi, Libya @MDPIOpenAccess @UCT_Research @RoySocChem @NRF_News @UCT_news

Today is my invited lecture titled #SolidStateNMR from small molecules to complex materials at @germn_rseq I will show what @lazarolab is doing in #NMR! #CopperComplexes #Materials


So proud to be the first author of our last great review now out on Coordination Chemistry Reviews #coppercomplexes #peptides #dopamine #CCR #unipv. Click here NOW and enjoy the article for FREE authors.elsevier.com/c/1fZd62Tz3xQ0w sciencedirect.com/science/articl…
📢Microwave synthetized mono- and bis-chlorinated amino acid Schiff base #CopperComplexes show #antibacterial activity. ➡️Read more at: mdpi.com/2673-8007/2/2/…

[Coordination Asymmetry] Arsenic | Copper | Cuprophilic interaction Article by Prof. Kensuke Naka and Dr. Hiroaki Imoto @pr_kit (Kyoto Institute of Technology) is available as Open Access #OrganoArsenic #CopperComplexes #Luminescence journal.csj.jp/doi/abs/10.124…
![CSJjournals_jp's tweet image. [Coordination Asymmetry]
Arsenic | Copper | Cuprophilic interaction
Article by Prof. Kensuke Naka and Dr. Hiroaki Imoto @pr_kit (Kyoto Institute of Technology) is available as Open Access
#OrganoArsenic #CopperComplexes #Luminescence
journal.csj.jp/doi/abs/10.124…](https://pbs.twimg.com/media/FFafRljaMAAP_PD.jpg)
Really beautiful work ! #coppercomplexes
New Paper! @ChemBioChem #Isoxazole‐Derived #Aroylhydrazones &Their Dinuclear #CopperComplexes Show #Antiproliferative Activity on #BreastCancer Cells with a Potentially Alternative Mechanism Of Action …mistry-europe.onlinelibrary.wiley.com/doi/epdf/10.10… Rt @CNRS_Paris @IPCM_Sorbonne @pucriooficial
Paper! "Binucleating #Hydrazonic Ligands and Their μ-Hydroxodi #copperComplexes as Promising Structural Motifs for Enhanced #Antitumor Activity" pubs.acs.org/doi/10.1021/ac… Rt @InorgChem @pucriooficial @MaxPlanckRos #MPLbioR @UNRoficial @UFJF_ @uff_br @ufmg #medicinalchemistry
New Paper! @ChemBioChem #Isoxazole‐Derived #Aroylhydrazones &Their Dinuclear #CopperComplexes Show #Antiproliferative Activity on #BreastCancer Cells with a Potentially Alternative Mechanism Of Action …mistry-europe.onlinelibrary.wiley.com/doi/epdf/10.10… Rt @IPCM_Sorbonne @pucriooficial #medicinalchemistry
Palanquin-Like Cu4Na4 Silsesquioxane Synthesis (via Oxidation of 1,1-bis(Diphenylphosphino)methane), Structure and Catalytic Activity in Alkane or Alcohol Oxidation with Peroxides sci.fo/5tf #Alkanes #HydrogenPeroxide #CopperComplexes

Color-tunable #CopperComplexes: Applications in solution-processed #OLEDs. Che @HKUniversity doi.wiley.com/10.1002/asia.2…

Today is my invited lecture titled #SolidStateNMR from small molecules to complex materials at @germn_rseq I will show what @lazarolab is doing in #NMR! #CopperComplexes #Materials


Synthesis, Spectral, Antimicrobial and In Vitro Antitumorous Studies of Copper Based Mulltidentate Thiosemicarbazones. bit.ly/3KtZO8A #Antitumorousstudies #Coppercomplexes #EPRspectra #gvalues #multidentate #chemistry #biochemistry #nanomaterial #analyticalchemistry
📢Microwave synthetized mono- and bis-chlorinated amino acid Schiff base #CopperComplexes show #antibacterial activity. ➡️Read more at: mdpi.com/2673-8007/2/2/…

Konstantin just presented his research on #coppercomplexes for #ATRP at #ACSSpring2024 ! read online here: pubs.rsc.org/en/content/art… @DaltonTrans Moreover he presented new results on teaching #FAIRdata in chemistry @NFDI4Chem !


Efficient Red Electroluminescent Copper Complexes with Fluorination-Balanced Dual Emission. Click the link below to read this free, open access article. doi.org/10.34133/resea… #OLED #LuminescentMaterials #CopperComplexes #OpticalMaterials

#Article Experimental-Theoretical Approach for the Chemical Detection of Glyphosate and Its Potential Interferents Using a Copper Complex Fluorescent Probe by Guilherme Martins, et al. doi.org/10.3390/chemos… @MDPIOpenAccess @unb_oficial @TUChemnitz @ULisboa_ #coppercomplexes

Color-tunable #CopperComplexes: Applications in solution-processed #OLEDs. Che @HKUniversity doi.wiley.com/10.1002/asia.2…

[Coordination Asymmetry] Arsenic | Copper | Cuprophilic interaction Article by Prof. Kensuke Naka and Dr. Hiroaki Imoto @pr_kit (Kyoto Institute of Technology) is available as Open Access #OrganoArsenic #CopperComplexes #Luminescence journal.csj.jp/doi/abs/10.124…
![CSJjournals_jp's tweet image. [Coordination Asymmetry]
Arsenic | Copper | Cuprophilic interaction
Article by Prof. Kensuke Naka and Dr. Hiroaki Imoto @pr_kit (Kyoto Institute of Technology) is available as Open Access
#OrganoArsenic #CopperComplexes #Luminescence
journal.csj.jp/doi/abs/10.124…](https://pbs.twimg.com/media/FFafRljaMAAP_PD.jpg)
Palanquin-Like Cu4Na4 Silsesquioxane Synthesis (via Oxidation of 1,1-bis(Diphenylphosphino)methane), Structure and Catalytic Activity in Alkane or Alcohol Oxidation with Peroxides sci.fo/5tf #Alkanes #HydrogenPeroxide #CopperComplexes

Something went wrong.
Something went wrong.
United States Trends
- 1. #BorderlessBanking N/A
- 2. Good Tuesday N/A
- 3. #AguilaNoCazaMosca N/A
- 4. #KeepBrawlAlive N/A
- 5. DoorDash N/A
- 6. #AMAs N/A
- 7. Globalstar N/A
- 8. Aang N/A
- 9. Artist of the Year N/A
- 10. Biden DOJ N/A
- 11. #PortfolioDay N/A
- 12. FACE Act N/A
- 13. Titleist N/A
- 14. Korra N/A
- 15. Happy 414 N/A
- 16. Meloni N/A
- 17. Core PPI N/A
- 18. Holocaust N/A
- 19. Ants N/A
- 20. Kevin Warsh N/A













